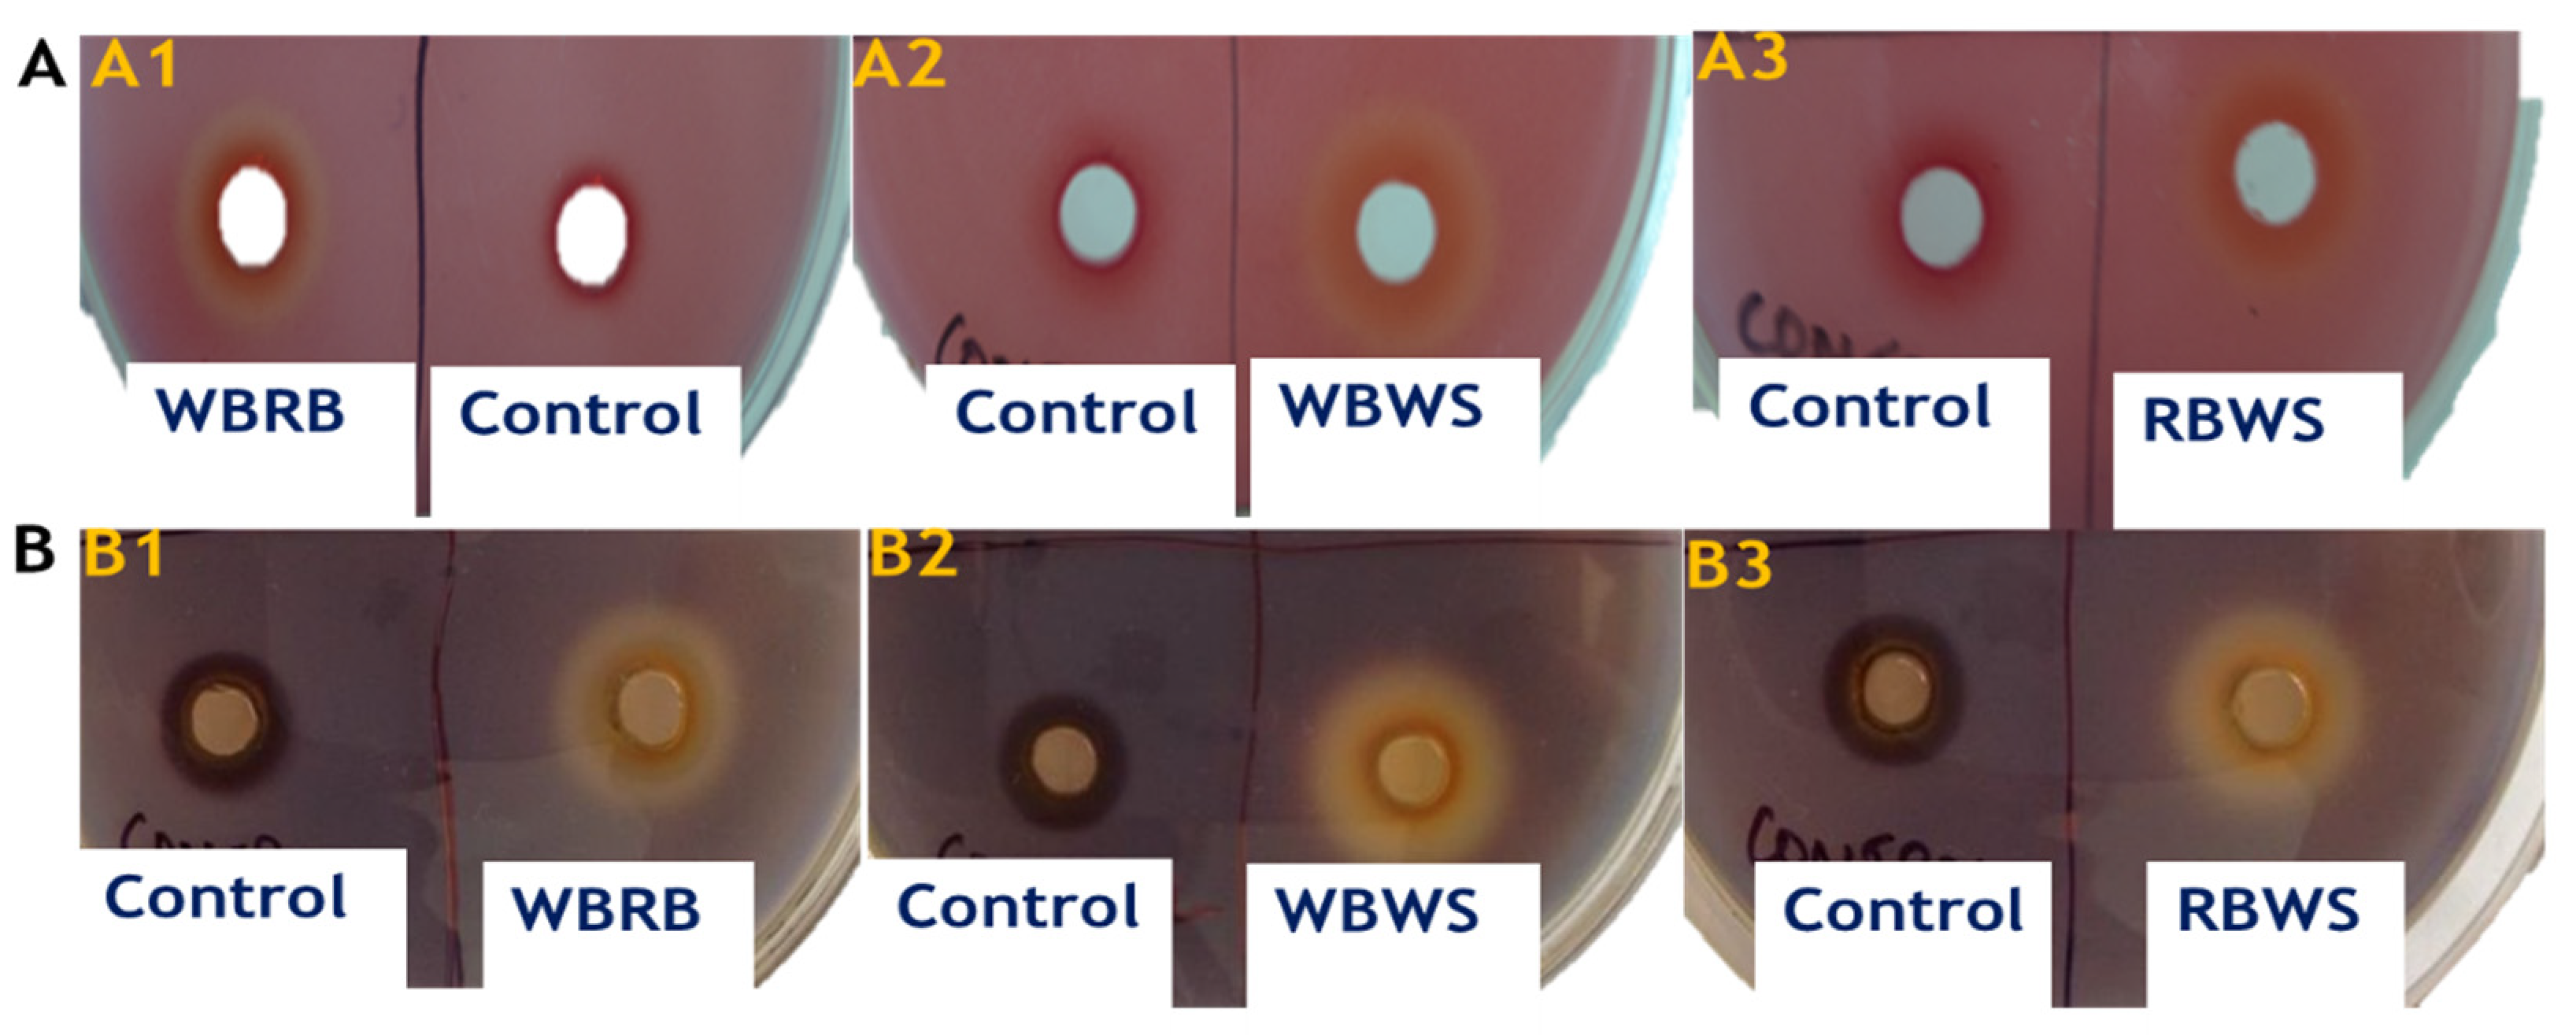

Sustainable Production of Lignocellulolytic Enzymes in Solid-State Fermentation of Agro-Industrial Waste: Application in Pumpkin (Cucurbita maxima) Juice Clarification
Abstract
1. Introduction
2. Materials and Methods
2.1. Agro-Industrial Waste
2.2. Fungi
2.3. Solid-State Fermentation
2.4. Extraction of Enzyme
2.5. Purification of Crude Enzyme
2.6. Protein Content
2.7. Analysis of Enzyme Activities
2.8. Application of Purified Enzyme Extracts in Clarification of Pumpkin Juice
2.9. Characteristics of Pumpkin Juice
2.10. Principal Component Analysis (PCA)
2.11. Statistical Analysis
3. Results and Discussion
3.1. Protein Content
3.2. Production of Lignocellulolytic Enzymes
3.3. Application of Purified Enzyme Extracts in Clarification of Pumpkin Juice
3.4. Principal Components Analysis (PCA)
4. Conclusions
Supplementary Materials
Author Contributions
Funding
Institutional Review Board Statement
Informed Consent Statement
Data Availability Statement
Conflicts of Interest
References
- AboSiada, O.A.; Negm, M.; Basiouny, M.; Fouad, M.; Elagroudy, S. Nutrient enrichment of agro–industrial waste using solid state fermentation. Microbiol. Res. J. Int. 2017, 22, 1–11. [Google Scholar] [CrossRef]
- Wang, B.; Dong, F.; Chen, M.; Zhu, J.; Tan, J.; Fu, X.; Wang, Y.; Chen, S. Advances in recycling and utilization of agricultural wastes in china: Based on environmental risk, crucial pathways, influencing factors, policy mechanism. Proc. Environ. Sci. 2016, 31, 12–17. [Google Scholar] [CrossRef]
- FEECO. Waste Transformation. Available online: https://feeco.com/waste-transformation/ (accessed on 29 April 2021).
- Freitas, L.C.; Barbosa, J.R.; da Costa, A.L.C.; Bezerra, F.W.F.; Pinto, R.H.H.; Carvalho Junior, R.N.D. From waste to sustainable industry: How can agro-industrial wastes help in the development of new products? Res. Conserv. Recycl. 2021, 169, 105466. [Google Scholar] [CrossRef]
- Oliveira, F.; Souza, C.E.; Peclat, V.R.O.L.; Salgado, J.M.; Ribeiro, B.D.; Coelho, M.A.Z.; Venâncio, A.; Belo, I. Optimization of lipase production by Aspergillus ibericus from oil cakes and its application in esterification reactions. Food Bioprod. Proc. 2017, 102, 268–277. [Google Scholar] [CrossRef]
- Chilakamarry, C.R.; Mimi Sakinah, A.M.; Zularisam, A.W.; Sirohi, R.; Khilji, I.A.; Ahmad, N.; Pandey, A. Advances in solid-state fermentation for bioconversion of agricultural wastes to value-added products: Opportunities and challenges. Biores. Technol. 2022, 343, 126065. [Google Scholar] [CrossRef]
- Saratale, G.D.; Kshirsagar, S.D.; Sampange, V.T.; Saratale, R.G.; Oh, S.-E.; Govindwar, S.P.; Oh, M.-K. Cellulolytic enzymes production by utilizing agricultural wastes under solid state fermentation and its application for biohydrogen production. App. Biochem. Biotechnol. 2014, 174, 2801–2817. [Google Scholar] [CrossRef] [PubMed]
- Ferreira, J.A.; Mahboubi, A.; Lennartsson, P.R.; Taherzadeh, M.J. Waste biorefineries using filamentous ascomycetes fungi: Present status and future prospects. Biores. Technol. 2016, 215, 334–345. [Google Scholar] [CrossRef] [PubMed]
- Ramamoorthy, N.K.; Sambavi, T.R.; Renganathan, S. A study on cellulase production from a mixture of lignocellulosic wastes. Process Biochem. 2019, 83, 148–158. [Google Scholar] [CrossRef]
- Marín, M.; Sánchez, A.; Artola, A. Production and recovery of cellulases through solid-state fermentation of selected lignocellulosic wastes. J. Clean. Product. 2019, 209, 937–946. [Google Scholar] [CrossRef]
- Mtui, G.Y. Recent advances in pretreatment of lignocellulosic wastes and production of value added products. Afr. J. Biotechnol. 2009, 8, 1398–1415. [Google Scholar]
- Putri, D.N.; Khootama, A.; Perdani, M.S.; Utami, T.S.; Hermansyah, H. Optimization of Aspergillus niger lipase production by solid state fermentation of agro-industrial waste. Energy Rep. 2020, 6, 331–335. [Google Scholar] [CrossRef]
- De la Rosa, O.; Múñiz-Marquez, D.B.; Contreras-Esquivel, J.C.; Wong-Paz, J.E.; Rodríguez-Herrera, R.; Aguilar, C.N. Improving the fructooligosaccharides production by solid-state fermentation. Biocat. Agric. Biotechnol. 2020, 27, 101704. [Google Scholar] [CrossRef]
- Marzo, C.; Díaz, A.B.; Caro, I.; Blandino, A. Valorization of agro-industrial wastes to produce hydrolytic enzymes by fungal solid-state fermentation. Waste Manag. Res. J. Int. Solid Wastes Public Clean. Assoc. 2019, 37, 149–156. [Google Scholar] [CrossRef] [PubMed]
- Toushik, S.H.; Lee, K.-T.; Lee, J.-S.; Kim, K.-S. Functional applications of lignocellulolytic enzymes in the fruit and vegetable processing industries. J. Food Sci. 2017, 82, 585–593. [Google Scholar] [CrossRef] [PubMed]
- Llimós, J.; Martínez-Avila, O.; Marti, E.; Corchado-Lopo, C.; Llenas, L.; Gea, T.; Ponsá, S. Brewer’s spent grain biotransformation to produce lignocellulolytic enzymes and polyhydroxyalkanoates in a two-stage valorization scheme. Biom. Convers. Biorefin. 2020, 1–12. [Google Scholar] [CrossRef]
- Indesh, A.; Sushma, G.; Sawinder, K.; Swetlana, N.; Monika, T. Utilization of orange peel and wheat straw for cellulase enzyme production from Aspergillus terreus MTCC7600. Eco. Environ. Cons 2016, 22, 307–313. [Google Scholar]
- Singhania, R.R.; Sukumaran, R.K.; Pillai, A.; Prema, P.; Szakacs, G.; Pandey, A. Solid-state fermentation of lignocellulosic substrates for cellulase production by Trichoderma reesei NRRL 11460. Indian J. Biotechnol. 2006, 5, 332–336. [Google Scholar]
- Iqbal, H.M.N.; Ishtiaq, A.; Muhammad Anjum, Z.; Muhammad, I. Purification and characterization of the kinetic parameters of cellulase produced from wheat straw by Trichoderma viride under SSF and its detergent compatibility. Adv. Biosci. Biotechnol. 2011, 2, 149–156. [Google Scholar] [CrossRef]
- Bradford, M.M. A rapid and sensitive method for the quantitation of microgram quantities of protein utilizing the principle of protein-dye binding. Anal. Biochem. 1976, 72, 248–254. [Google Scholar] [CrossRef]
- Pal, S.; Banik, S.P.; Khowala, S. Mustard stalk and straw: A new source for production of lignocellulolytic enzymes by the fungus Termitomyces clypeatus and as a substrate for saccharification. Ind. Crop. Prod. 2013, 41, 283–288. [Google Scholar] [CrossRef]
- Dorris, M.R.; Voss, D.M.; Bollom, M.A.; Krawiec-Thayer, M.P.; Bolling, B.W. Browning index of anthocyanin-rich fruit juice depends on ph and anthocyanin loss more than the gain of soluble polymeric pigments. J. Food Sci. 2018, 83, 911–921. [Google Scholar] [CrossRef]
- Abdullah, A.G.L.; Sulaiman, N.M.; Aroua, M.K.; Megat Mohd Noor, M.J. Response surface optimization of conditions for clarification of carambola fruit juice using a commercial enzyme. J. Food Eng. 2007, 81, 65–71. [Google Scholar] [CrossRef]
- St-Germain, G.; Summerbell, R. Identifying Filamentous Fungi: A Clinical Laboratory Handbook; Star Publishing Company: Belmont, CA, USA, 1996. [Google Scholar]
- Brozzoli, V.; Bartocci, S.; Terramoccia, S.; Contò, G.; Federici, F.; D’Annibale, A.; Petruccioli, M. Stoned olive pomace fermentation with Pleurotus species and its evaluation as a possible animal feed. Enzym. Microb. Technol. 2010, 46, 223–228. [Google Scholar] [CrossRef]
- Sousa, D.; Venâncio, A.; Belo, I.; Salgado, J.M. Mediterranean agro-industrial wastes as valuable substrates for lignocellulolytic enzymes and protein production by solid-state fermentation. J. Sci. Food Agric. 2018, 98, 5248–5256. [Google Scholar] [CrossRef] [PubMed]
- Shruthi, K.; Yadav, P.S.; Prasad, B.V.S.; Chandra, M.S. Cellulase production by Aspergillus unguis in solid state fermentation. J. For. Res. 2019, 30, 205–212. [Google Scholar] [CrossRef]
- Hu, T.; Zhou, Y.; Dai, L.; Wang, Y.; Liu, D.; Zhang, J.; Liu, H. Enhanced cellulase production by solid state fermentation with polyurethane foam as inert supports. Proc. Eng. 2011, 18, 335–340. [Google Scholar] [CrossRef][Green Version]
- Leite, P.; Salgado, J.M.; Venâncio, A.; Domínguez, J.M.; Belo, I. Ultrasounds pretreatment of olive pomace to improve xylanase and cellulase production by solid-state fermentation. Biores. Technol. 2016, 214, 737–746. [Google Scholar] [CrossRef] [PubMed]
- Yang, S.Q.; Yan, Q.J.; Jiang, Z.Q.; Li, L.T.; Tian, H.M.; Wang, Y.Z. High-level of xylanase production by the thermophilic Paecilomyces themophila J18 on wheat straw in solid-state fermentation. Biores. Technol. 2006, 97, 1794–1800. [Google Scholar] [CrossRef]
- Brijwani, K.; Oberoi, H.S.; Vadlani, P.V. Production of a cellulolytic enzyme system in mixed-culture solid-state fermentation of soybean hulls supplemented with wheat bran. Process Biochem. 2010, 45, 120–128. [Google Scholar] [CrossRef]
- Leite, P.; Sousa, D.; Fernandes, H.; Ferreira, M.; Costa, A.R.; Filipe, D.; Gonçalves, M.; Peres, H.; Belo, I.; Salgado, J.M. Recent advances in production of lignocellulolytic enzymes by solid-state fermentation of agro-industrial wastes. Curr. Opin. Green Sustain. Chem. 2021, 27, 100407. [Google Scholar] [CrossRef]
- Shahrestani, H.; Taheri-Kafrani, A.; Soozanipour, A.; Tavakoli, O. Enzymatic clarification of fruit juices using xylanase immobilized on 1,3,5-triazine-functionalized silica-encapsulated magnetic nanoparticles. Biochem. Eng. J. 2016, 109, 51–58. [Google Scholar] [CrossRef]
- Shrestha, L.; Kulig, B.; Moscetti, R.; Massantini, R.; Pawelzik, E.; Hensel, O.; Sturm, B. Optimisation of physical and chemical treatments to control browning development and enzymatic activity on fresh-cut apple slices. Foods 2020, 9, 76. [Google Scholar] [CrossRef]
- Nagar, S.; Mittal, A.; Gupta, V.K. Enzymatic clarification of fruit juices (apple, pineapple, and tomato) using purified Bacillus pumilus SV-85S xylanase. Biotechnol. Bioproc. Eng. 2012, 17, 1165–1175. [Google Scholar] [CrossRef]
- Sandri, I.G.; Piemolini-Barreto, L.T.; Fontana, R.C.; Silveira, M.M.D. Application of enzymatic preparations to produce araçá pulp and juice. Food Sci. Technol. 2014, 34, 657–662. [Google Scholar] [CrossRef][Green Version]
- Sharma, H.P.; Patel, H.; Sugandha. Enzymatic added extraction and clarification of fruit juices–A review. Crit. Rev. Food Sci. Nutr. 2017, 57, 1215–1227. [Google Scholar] [CrossRef]

| Fusarium oxysporum MTCC 7229 | Macroscopic characteristics | ||||
| Color | Form | Elevation | Texture | Color on reverse side | |
| Creamy white | Irregular | Raised | Cottony and loosely packed | Pink tinge | |
| Microscopic characteristics | |||||
| ![]() | ||||
| Substrate | Protein (mg/g Substrate) | CMCase Activity (U/g Substrate) | Specific Activity (U/mg Protein) | Xylanase Activity (U/g Substrate) | Specific Activity (U/mg Protein) |
|---|---|---|---|---|---|
| Control | 0.98 ± 0.15 a | ND † | ND | ND | ND |
| WBRB | 3.07 ± 0.02 b | 5.89 ± 0.06 a | 1.91 ± 0.25 b | 13.77 ± 0.28 c | 4.48 ± 0.16 c |
| WBWS | 3.90 ± 0.02 d | 6.84 ± 0.07 c | 1.75 ± 0.03 a | 12.82 ± 0.10 b | 3.29 ± 0.14 b |
| RBWS | 3.35 ± 0.01 c | 6.43 ± 0.47 b | 1.92 ± 0.10 b | 10.08 ± 0.03 a | 3 ± 0.07 a |
| Enzyme Extract (%) | Substrate | ||||||||
|---|---|---|---|---|---|---|---|---|---|
| WBRB | WBWS | RBWS | |||||||
| Juice Yield (%) | Browning Index | Clarity (%T) | Juice Yield (%) | Browning Index | Clarity (%T) | Juice Yield (%) | Browning Index | Clarity (%T) | |
| Control | 29.60 ± 1.08 a | 1.03 ± 0.08 c | 20.96 ± 1.62 a | 23.70 ± 1.15 a | 1.30 ± 0.28 c | 12.26 ± 0.62 a | 16.30 ± 0.34 a | 1.63 ± 0.26 c | 5.31 ± 1.22 a |
| 0.50 | 37.20 ± 0.14 b | 0.77 ± 0.10 b | 38.73 ± 1.24 b | 35.20 ± 2.10 b | 0.78 ± 0.08 b | 37.83 ± 1.10 b | 32 ± 1.47 b | 0.81 ± 0.06 b | 35.75 ± 2.90 b |
| 0.70 | 40.10 ± 0.04 c | 0.74 ± 0.15 b | 41.12 ± 1.73 c | 38.90 ± 3.17 c | 0.76 ± 1.08 b | 39.41 ± 0.04 c | 36.40 ± 0.86 b | 0.78 ± 0.11 b | 38.29 ± 1.08 c |
| 0.90 | 45.20 ± 0.17 d | 0.73 ± 0.19 a | 42.91 ± 2.11 d | 41.30 ± 1.50 d | 0.74 ± 1.65 a | 41.80 ± 1.28 d | 40.30 ± 0.72 d | 0.74 ± 0.23 a | 41.22 ± 1.93 d |
| 1.20 | 47.30 ± 0.09 e | 0.72 ± 0.03 a | 44.24 ± 2.09 e | 44.40 ± 1.75 e | 0.73 ± 0.09 a | 42.76 ± 2.28 e | 43.90 ± 0.58 e | 0.73 ± 0.13 a | 42.31 ± 1.52 e |
| 1.50 | 50.30 ± 0.13 f | 0.71 ± 0.21 a | 45.12 ± 1.18 f | 47.30 ± 1.82 f | 0.71 ± 0.04 a | 44.29 ± 2.26 f | 45.70 ± 0.81 f | 0.73 ± 0.28 a | 43.13 ± 1.09 f |
| 1.80 | 53.30 ± 0.18 g | 0.71 ± 0.13 a | 45.91 ± 1.10 g | 50.40 ± 2.21 g | 0.70 ± 0.05 a | 45.48 ± 3.58 g | 48.70 ± 1.93 g | 0.71 ± 0.14 a | 44.34 ± 1.66 g |
| 2.10 | 54.70 ± 0.77 h | 0.70 ± 0.18 a | 46.28 ± 2.08 h | 51.80 ± 2.08 h | 0.70 ± 0.08 a | 45.61 ± 3.92 h | 49.40 ± 1.06 h | 0.71 ± 0.19 a | 44.81 ± 1.82 h |
| 2.40 | 55.60 ± 1.54 i | 0.70 ± 0.03 a | 46.83 ± 2.10 i | 53.10 ± 2.68 i | 0.70 ± 0.10 a | 45.78 ± 3.30 i | 50.30 ± 1.15 i | 0.70 ± 0.11 a | 45.53 ± 1.16 i |
Publisher’s Note: MDPI stays neutral with regard to jurisdictional claims in published maps and institutional affiliations. |
© 2021 by the authors. Licensee MDPI, Basel, Switzerland. This article is an open access article distributed under the terms and conditions of the Creative Commons Attribution (CC BY) license (https://creativecommons.org/licenses/by/4.0/).
Share and Cite
Rana, P.; Inbaraj, B.S.; Gurumayum, S.; Sridhar, K. Sustainable Production of Lignocellulolytic Enzymes in Solid-State Fermentation of Agro-Industrial Waste: Application in Pumpkin (Cucurbita maxima) Juice Clarification. Agronomy 2021, 11, 2379. https://doi.org/10.3390/agronomy11122379
Rana P, Inbaraj BS, Gurumayum S, Sridhar K. Sustainable Production of Lignocellulolytic Enzymes in Solid-State Fermentation of Agro-Industrial Waste: Application in Pumpkin (Cucurbita maxima) Juice Clarification. Agronomy. 2021; 11(12):2379. https://doi.org/10.3390/agronomy11122379
Chicago/Turabian StyleRana, Priya, Baskaran Stephen Inbaraj, Sushma Gurumayum, and Kandi Sridhar. 2021. "Sustainable Production of Lignocellulolytic Enzymes in Solid-State Fermentation of Agro-Industrial Waste: Application in Pumpkin (Cucurbita maxima) Juice Clarification" Agronomy 11, no. 12: 2379. https://doi.org/10.3390/agronomy11122379
APA StyleRana, P., Inbaraj, B. S., Gurumayum, S., & Sridhar, K. (2021). Sustainable Production of Lignocellulolytic Enzymes in Solid-State Fermentation of Agro-Industrial Waste: Application in Pumpkin (Cucurbita maxima) Juice Clarification. Agronomy, 11(12), 2379. https://doi.org/10.3390/agronomy11122379


